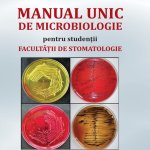

MEDICINĂ SPAȚIALĂ
October 17, 2025
MANUAL UNIC DE MICROBIOLOGIE PENTRU STUDENȚII FACULTĂȚII DE STOMATOLOGIE
October 17, 2025PRACTICAL GUIDE FOR MEDICAL PHYSIOLOGY 2nd Edition Revised and added
Autori: Ioana Raluca Papacocea, Mariana Cătălina Ciornei, Cristian Scheau, Grațiela Livia Mihai, Mădălina Coman Stanemir, Maria Marinescu, Sofia Maria Timpuriu, Radu Vrabie.
Titlu: PRACTICAL GUIDE FOR MEDICAL PHYSIOLOGY 2nd Edition Revised and added
ISBN: 978-606-011-342-3
Apărut: Octombrie 2025
Pagini: 142
ISBN: 978-606-011-342-3
Contents
Chapter 1. Water in the body. Determination of fluid compartments
Chapter 2. Blood, plasma and erythrocytes
Chapter 3. Leukocytes
Chapter 4. Exploration of Platelets
Chapter 5. Hemodynamics
Chapter 6. Investigation of kidney function
Chapter 7. Respiratory system exploration
Legat de:
Fiziologie medicală: Manual de lucrări practice
Practical guide for medical physiology


